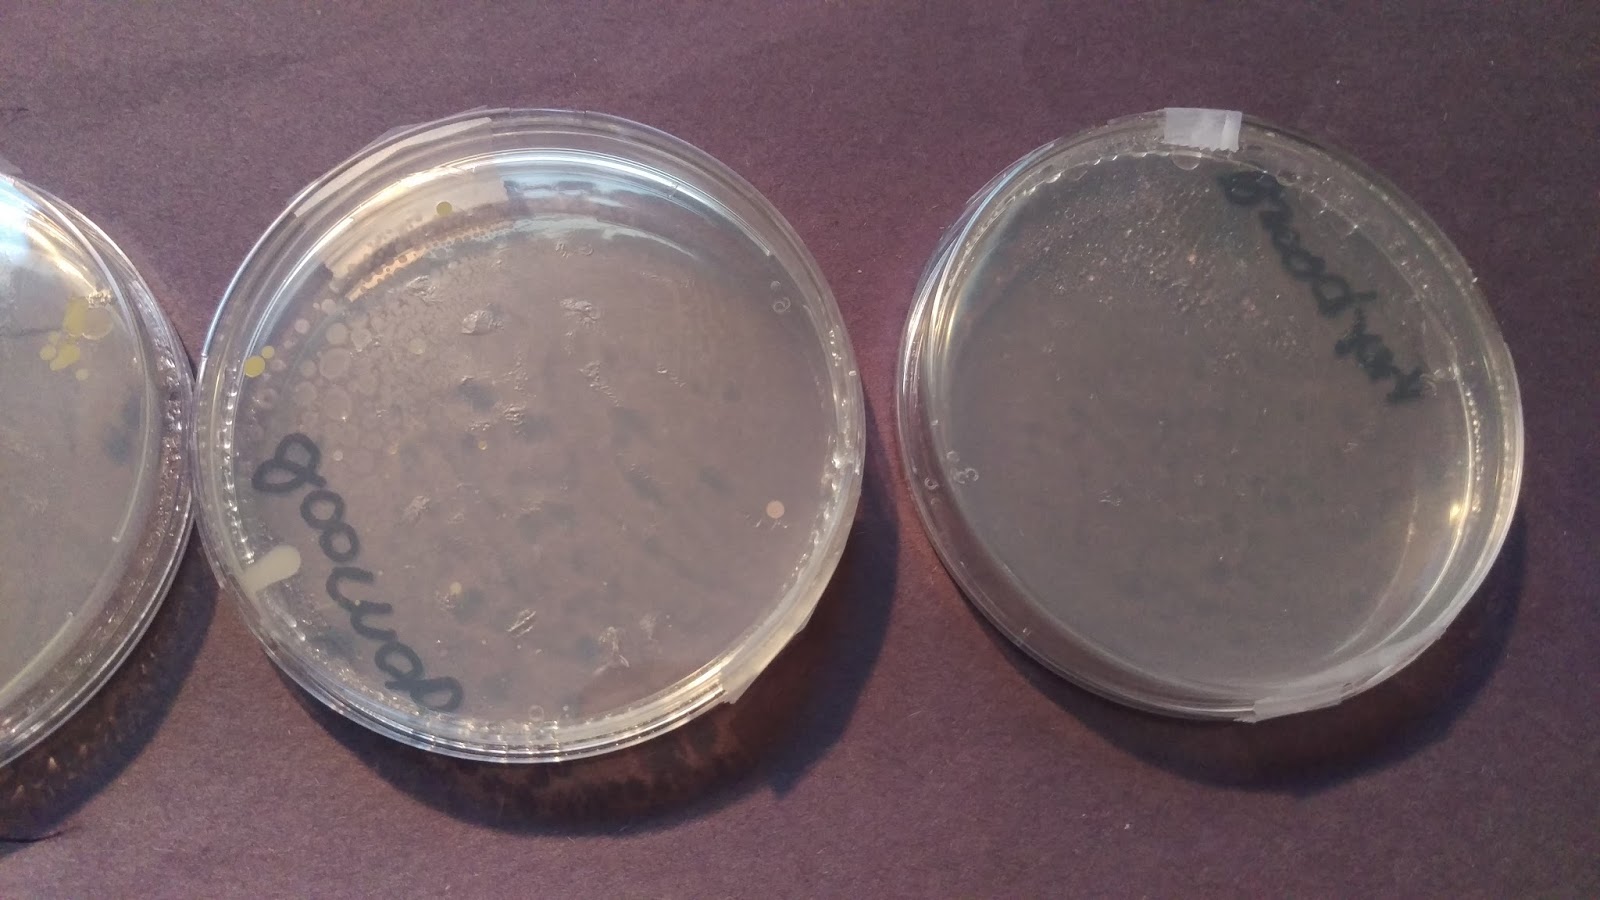
The Cool Science Dad: Science Fair Project - Bacterial Growth Day 4

Bacteria Growth Science Fair Project Growing Bacteria Scienc
Science fair project bacteria experiment bacteria project for school A shocking bacteria science experiment: grow a germ farm
Bacteria Science Kit Petri Dishes with Agar and Swabs | Top Science
Science fair growing bacteria Growing bacteria science fair projects Got bacteria? science fair project
bacteria science fair board
Bacteria growth science fair projectBacteria science kit petri dishes with agar and swabs growing bacteria science fair projectsgrowing bacteria kit.
A step-by-step microbiology science project for kidsgrowing bacteria science fair project A shocking bacteria science experiment: grow a germ farmscience fair bacteria growth.

science fair projects microbiology
The cool science dad: science fair projectA shocking bacteria science experiment: grow a germ farm bacteria science kit petri dishes with agar and swabsscience fair growing bacteria.
growing bacteria in a petri dish {stem activity for kids}The cool science dad: science fair project Welcome to the krazy kingdom: bladen's science fair projectScience fair growing bacteria.

science fair experiment: grow bacteria
Got bacteria? science fair projectQuick growing bacteria science fair project bacteria science fair project kit (10-pack). great for students ...bacteria growth science fair project.
8th grade science fair bacteria tri-foldGrowing bacteria for science fairs The cool science dad: science fair projectgrowing bacteria for science fairs.

science fair project bacteria experiment
Swab & growscience fair project mold garden Science fair bacteria growthEasy science fair project ideas for all ages (and picking the perfect.
Easy science fair project ideas for all ages (and picking the perfect ...8th grade science fair bacteria tri-fold Got bacteria?Science fair projects microbiology.

Bacteria growth science fair project
Welcome to the krazy kingdom: bladen's science fair projectbacteria growth science fair project A step-by-step microbiology science project for kidsscience fair growing bacteria.
Swab & growbacteria science fair board Bacteria science fair boardThe cool science dad: science fair project.
Growing bacteria in petri dishes experiment
The cool science dad: science fair projectThe cool science dad: science fair project Science fair project mold gardenBacteria science fair projects.
Growing bacteria in a petri dish {stem activity for kids}Science fair experiment: grow bacteria Bacteria project for schoolGrowing bacteria science fair project.

growing bacteria in petri dishes experiment
bacteria science fair projectsBacteria science fair project kit (10-pack). great for students Growing bacteria kitGrowing bacteria science fair projects.
A shocking bacteria science experiment: grow a germ farmgrowing bacteria science fair projects Bacteria science fair boardQuick growing bacteria science fair project.

Got bacteria?
.
.

Science Fair Project Mold Garden

Welcome to the Krazy Kingdom: Bladen's Science Fair Project - "What

Science Fair Project Bacteria Experiment - vrogue.co

Bacteria Science Kit Petri Dishes with Agar and Swabs | Top Science